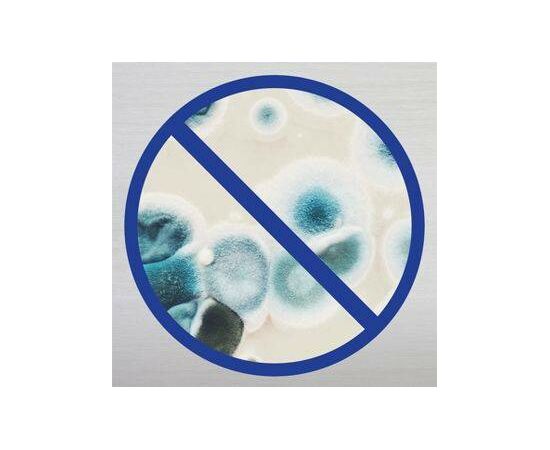

O spray desinfetante Lysol ajuda a proteger sua família e a mantê-la saudável. Foi projectado para proteger contra germes e pode matar 99,9% dos vírus e bactérias em superfícies duras, quando usados conforme as instruções. De balcões a sofás, pode contar com o Lysol para matar 99,9% das bactérias. Este spray elimina odores e mata 99,9% de mofo e vírus na maioria das superfícies domésticas. Higieniza superfícies macias e desodoriza o ar.
Não foram encontradas mensagens